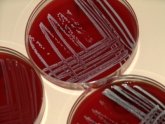

- Aktuelles
- Themen
- Tiere & Lebensmittel
- Ordnung
- Bevölkerungsschutz
- Auto, Verkehr & Mobilität
- Geoinformation, Kataster und Vermessung
- Gesundheit
- Anmeldung von Kindertagespflege
- Pflicht zur Meldung beim Gesundheitsamt
- Förderung Medizinstudierender
- Medizinalaufsicht, Apothekenaufsicht, Masernschutz
- Wegweiser Gesundheit
- Beratung & Information
- BIGS - Gesundheit & Selbsthilfe
- Infektionskrankheiten
- Gesundheitsbezogener Hitzeschutz
- Trinkwasser und Umwelt
- Gesundheitskonferenz und Gesundheitsberichte
- Kinder & Jugendliche
- Koordinationsstelle für Ernährung und Bewegung im Offenen Ganztag
- Kommunale Gesundheitsförderung
- Bauen, Wohnen, Immissionen
- Jugend
- Bildung
- Kommunales Integrationszentrum
- Kommunales Integrationszentrum Kreis Gütersloh
- Team des Kommunalen Integrationszentrums
- Aktuelles aus dem Kommunalen Integrationszentrum
- Integrationskonzept 2025
- Integration durch Bildung
- Integration als Querschnittsaufgabe
- Kommunales Integrationsmanagement (KIM NRW)
- KOMM-AN NRW Förderung -Ehrenamtliches Engagement
- Wegweiser Integration im Kreis Gütersloh
- Soziales
- Jobcenter Kreis Gütersloh
- Energie & Klima
- Umwelt
- Wasser
- Unser Kreis
- Karriere
Trinkwasser und Umwelt

4uphoto, © Filipebvarela - Fotolia
Trinkwasser
Auf dieser Seite erhalten Sie Informationen zu den folgenden Themenbereichen:
Mehr

Umwelt
Auf dieser Seite erhalten Sie Informationen zum Thema Umwelt.
Mehr
© emeraldphoto - Fotolia
Überwachung der Tätigkeiten mit Krankheitserregern
Auf dieser Seite erhalten Sie Informationen zum Thema Überwachung der Tätigkeiten mit Krankheitserregern.
Mehr

Informationen zu PFAS
Auf dieser Seite erhalten Sie Informationen zum Thema PFAS (per- und polyfluorierte Alkylsubstanzen
Mehr